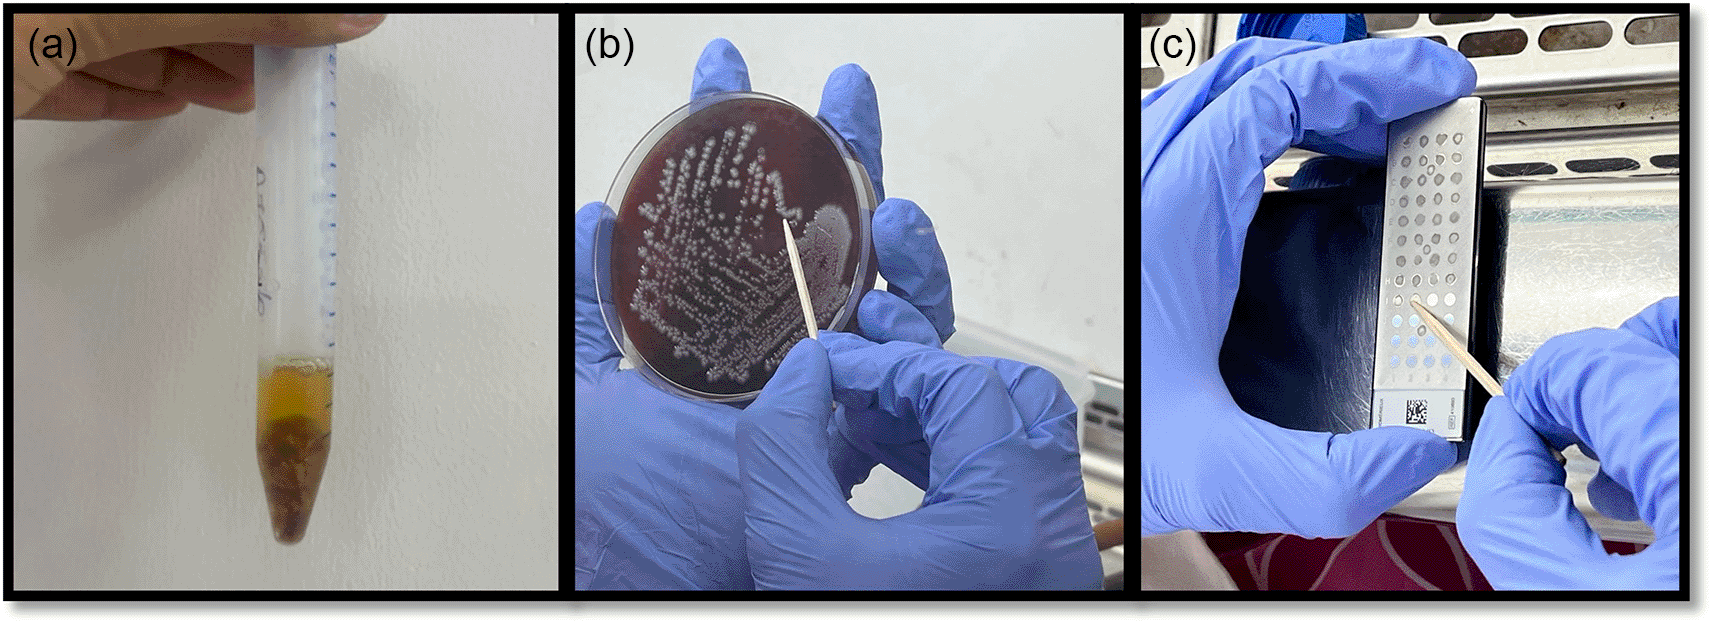
7680cb16-139e-4555-8c8c-488eb0fefeaf_figure3.gif

Keywords
chitosan, tetracycline, diabetes mellitus, chronic periodontitis, local drug delivery
This article is included in the Manipal Academy of Higher Education gateway.
Periodontal disease is a significant complication in patients with type-2 diabetes mellitus, further complicated by impaired immune response and increased susceptibility to infections. Effective management is essential as it influences both oral health and glycemic control. Traditional therapies frequently prove inadequate, necessitating the exploration of adjunctive treatments. Chitosan, known for its antibacterial, anti-inflammatory, and regenerative properties, offers potential benefits due to its non-toxicity, biodegradability, and biocompatibility. This study aims to systematically compare and evaluate the clinical outcomes and antimicrobial efficacy of 2mg resorbable Chitosan membranes versus 2mg resorbable tetracycline fibers (suspended in 25mg collagen) when used as adjuncts to scaling and root planing in patients with type-2 diabetes mellitus undergoing periodontal maintenance.
In parallel study design, 26 patients with type II diabetes mellitus, undergoing maintenance therapy and diagnosed with periodontitis, were treated with scaling and root planing. Test group was given chitosan membranes, while control group received tetracycline fibers as local drug delivery agents in residual pockets with depth of 5mm or more. Clinical evaluations, including Plaque Index, Modified Sulcus Bleeding Index, probing pocket depth, attachment loss, and microbiological analysis, were conducted at baseline and again at 3 months. This trial was prospectively registered with Clinical Trials Registry – India (Trial REF/2022/04/053476; Registration number: CTRI/2023/10/058766).
Both groups showed significant improvements in plaque index (PI), sulcus bleeding index (SBI), probing pocket depth (PD), and clinical attachment level (CAL) from baseline to three months, with no significant intergroup differences. The presence of Streptococcus mitis/oralis did not differ significantly between groups at any point. Actinomyces israelii and Fusobacterium nucleatum showed significant differences at baseline but not at three months.
Within the limits of the study, chitosan membrane showed similar results to tetracycline fibers at 3 months, making it a promising alternate modality in maintenance patients with chronic periodontitis.
chitosan, tetracycline, diabetes mellitus, chronic periodontitis, local drug delivery
Chronic periodontitis is an infectious condition characterized by inflammation in the supporting tissues of the teeth, leading to pocket formation, gingival recession, and gradual loss of attachment and bone.1 As periodontal pockets deepen, further gingival recession and tooth mobility frequently occur.2 The oral cavity harbors a diverse microflora, with approximately 500 bacterial taxa thriving in the warm, nutrient-rich, anaerobic environment of periodontal pockets.3 Initially dominated by aerobic and facultative anaerobic organisms, subgingival plaque evolves to be dominated by strictly anaerobic species, which contribute significantly to the pathogenesis of periodontal disease.2
Diabetes mellitus (DM) is marked by elevated glucose levels in blood due to dysfunctional sugar, lipid, and protein metabolism. Chronic hyperglycemia can damage various organs, including the kidneys, heart, nerves, and eyes. There is a strong link between DM and periodontitis, with diabetics being at higher risk due to factors like altered immune response, reduced bone turnover, microvascular changes, and impaired wound healing.4 Periodontitis is considered the sixth complication of diabetes, with a higher prevalence in diabetics (59.6%) compared to non-diabetics (39%). Studies show that diabetics have more severe periodontal disease, including greater attachment loss, alveolar bone loss, bleeding on probing, and tooth mobility.5 Diabetes affects periodontal health through tissue degeneration and calcified bodies around gingival blood vessels. Impaired defense mechanisms, increased infection susceptibility, and reduced healing capacity with altered collagen metabolism contribute to the increased periodontal destruction in diabetics.4
The primary goals of periodontal therapy are to control, eradicate, and inhibit pathogenic microbes. Conventional treatments, such as mechanical plaque management, are time-consuming, require skilled professionals, and may be uncomfortable for patients. Systemic antibiotics are sometimes necessary to target bacteria that infiltrate the gingiva and spread throughout the oral cavity. For patients with significant periodontal destruction or immune-compromising conditions such as diabetes, periodontal therapy combined with systemic antibiotics is utilized to manage periodontal infections. This combined approach effectively suppresses specific pathogenic microbial species and facilitates the rapid establishment of a host-compatible microbiota.6 However, their use must be carefully evaluated due to potential undesirable effects. Systemic antibiotics often become diluted at the site of action, leading to sub-therapeutic levels that can promote microbial resistance. Additionally, elevated plasma levels of antibiotics can cause side effects like depression, tachycardia, gastrointestinal intolerance, and hypersensitivity.2
With systemic antibiotics presenting drawbacks, there’s a notable shift towards targeted antimicrobial delivery in periodontal therapy. The demand for sustained-release devices directly inserted into periodontal pockets is rising, offering significant advantages. These devices not only circumvent undesirable systemic side effects but also minimize local discomfort for patients, thereby improving treatment compliance. Biodegradable polymers, renowned for their non-toxicity and high biocompatibility, are increasingly preferred for drug delivery in periodontics due to their ability to gradually release medications at the target site.2
Chitosan, derived from chitin, has surged in dental research due to its multifaceted biomedical applications, spanning antibacterial, anti-inflammatory, wound healing, and tissue regeneration.2 Its non-toxic, biodegradable, and biocompatible nature underpins these benefits, with mechanisms including membrane disruption or cell wall puncturing, effectively suppressing bacterial activity.2 Chitosan’s mucoadhesive property, facilitated by interactions with mucin proteins, further enhances its efficacy.7 Notably, FDA approval for tissue engineering underscores its safety and efficacy, positioning chitosan as a promising avenue for periodontal therapy.8 Intriguingly, research suggests potential in mitigating diabetes-associated glucose and lipid dysregulation, hinting at broader therapeutic implications.7
Locally, a range of broad-spectrum antibiotics, including metronidazole, doxycycline, minocycline, and tetracycline and its derivatives, have been commonly utilized.9 Tetracycline fibers have particularly garnered attention in chronic periodontitis treatment, offering high antibiotic concentrations directly in the periodontal pocket.10 Tetracycline’s unique ability to achieve significant concentrations in crevicular fluid surpasses other antibiotics’ capabilities in serum.10 Moreover, studies by Golub et al. suggest that tetracycline can prevent collagen degradation, collagenase activity, and bone resorption.11 Notably, tetracycline presents advantages such as low dosage requirements, minimal adverse effects, and self-resorption.2
Mass spectrometry (MS) is a powerful analytical technique involving the ionization of chemical compounds into charged molecules, measured by their mass-to-charge ratio (m/z). The introduction of matrix-assisted laser desorption ionization (MALDI) has revolutionized MS, especially for large biological molecules like proteins. In MALDI MS, samples are embedded in an organic matrix solution, crystallizing together upon drying. A laser beam ionizes the sample within the matrix, generating singly protonated ions. Time-of-flight (TOF) analyzers are then used to measure the ions’ m/z ratios. MALDI-TOF MS is extensively used in microbiology for rapid identification of microorganisms. By comparing peptide mass fingerprints (PMFs) to proteomic databases, or correlating biomarker masses, unknown organisms can be identified efficiently.12
This study aims to fill a critical gap by investigating the impact of resorbable chitosan membrane and tetracycline fibers as adjuncts to scaling and root planing (SRP) in Type-2 diabetes patients undergoing periodontal maintenance. Despite the importance of managing periodontitis in diabetic individuals, no research has explored the outcomes of chitosan in this context. By evaluating clinical and microbiological parameters, we seek to compare the efficacy of these interventions, shedding light on their potential role in improving periodontal health in diabetic patients during maintenance therapy.
This prospective, parallel, randomized control trial recruited patients from out-patient department of Periodontology at Manipal College of Dental Sciences, Mangalore, during the period spanning July 2023 to February 2024, with the patient enrolment done in July and August 2023. Ethical approval was obtained from the Institutional Ethics Committee of Manipal College of Dental Sciences Mangalore, Manipal Academy of Higher Education, Manipal (Protocol reference number: 22038). The study was registered with the Clinical Trials Registry – India (Trial REF/2022/04/053476; Registration number: CTRI/2023/10/058766). This randomized controlled trial was conducted and reported in accordance with the CONSORT 2025 guidelines (Figure 4) and with the principles outlined in the Declaration of Helsinki for research involving human subjects.

Sample size for this parallel design study was 26 patients in total, with 13 patients allocated to each group, using the below formula.
The study enrolled patients meeting specific criteria. Inclusion criteria required individuals with type-2 diabetes having HbA1c levels ≤7, aged 30 years or older, diagnosed with stage II or III grade B periodontitis, and already undergoing supportive periodontal therapy (SPT) while exhibiting residual pockets of ≥5 mm. Patients also needed Full Mouth Plaque Scores and Full Mouth Bleeding Scores below 25%. Exclusion criteria involved patients with additional systemic conditions beyond diabetes mellitus, recent use of certain medications like anti-inflammatory or immune-suppressants, or antimicrobial mouth rinses in the preceding two months. Smokers, individuals who have been on antibiotics or received periodontal treatment in the last six months, those with dental restorations or caries in the area of interest, and individuals with a history of tetracycline or chitosan allergy were excluded. Additionally, pregnant or lactating women were not included in the study.
Pre- treatment protocol: Participants were enrolled after providing written informed consent and receiving a comprehensive explanation of the procedures, benefits, and potential risks. Detailed history was documented, and complete oral examinations were conducted. HbA1c levels were analyzed to assess glycemic control, with only patients having levels equal to or less than 7 being selected for the study after confirmation with medical reports. Ethical approval was obtained from the Institutional Ethics Committee of Manipal College of Dental Sciences Mangalore, Manipal Academy of Higher Education, Manipal (Protocol reference number: 22038).
Each of the following clinical variables were evaluated: Plaque index according to Silness and Loe (1964),13 modified sulcular bleeding index by Mombelli et al. (1987),14 probing pocket depth (PPD), and clinical attachment level (CAL).
The treatment protocol involved several steps: patients with residual pockets after 3-6 months were examined using a mouth mirror and a William’s graduated periodontal probe under adequate lighting, after documentation of thorough medical and dental histories. Intra-oral periapical radiographs of the area of interest was taken. Customized acrylic stents ensured consistent probe placement. The same examiner documented all examination sets and clinical measurements for consistency across patients. The examiner received training and calibration for the various parameters evaluated in the study. Intra-examiner reliability was evaluated at baseline by randomly selecting ten participants. Initial therapy included oral hygiene instructions and supragingival instrumentation. Clinical parameters were evaluated at baseline and one week post-pre-treatment. Treatment allocation (scaling and root planing with either chitosan membrane or tetracycline fibers) was randomized using coin-toss method.
a) Blood agar plates- one plate per sample
b) 2 ml Brain Heart Infusion (BHI) broth
c) 500 𝜇l of sterile phosphate buffer saline
d) 1 μl of a matrix solution that included 50%
Acetonitrile, 1% α-cyano-4-hydroxycinnamic acid, and 2.5% trifluoroacetic acid
16S rRNA gene primer - made up of 12.5 μL of TB Green® Premix Ex Taq™ II
(Takara Bio Inc., USA) and 2 μL of DNA samples
All the reagents were procured from Department of Microbiology, Kasturba Medical College, Mangalore.
Treatment: In the test group, patients received a 4 mm × 4 mm × 0.1 mm resorbable chitosan membrane of 1% (w/w) (Essence Biotech Research Laboratory, Kochi, Kerala, India) ( Figure 2), inserted into the periodontal pocket using tissue-holding forceps until maximum resistance was felt. In the control group, patients received Periodontal Plus AB – 2 mg tetracycline HCl ( Figure 1) impregnated in 25 mg collagen (Advanced Biotech Products Pvt. Ltd., Tamil Nadu, India), filled into the pocket surrounding the tooth up to the gingival margin. The treatment sites in both groups were covered with Coe-Pack, with patients advised to return for dressing replacement if dislodged seven days before. They were instructed to refrain from brushing, using interdental aids, or eating hard/crusty foods until the dressing was removed. Oral hygiene instructions were reinforced.
Microbiological assay: Before the application of the local drug delivery agent, samples of subgingival plaque were collected using sterile curettes from designated areas within the pocket’s most apical region. Supragingival plaque was removed prior to subgingival plaque collection to prevent contamination. For the aerobic analysis, the collected plaque samples were directly inoculated onto blood agar plates (one plate per sample) and then incubated at 37°C to encourage bacterial growth. Conversely, for the anaerobic analysis, the plaque samples were inoculated into 2 ml Brain Heart Infusion (BHI) broth and maintained anaerobically at 37°C for 48 hours, after which bacteria from the BHI broth were sub-cultured onto blood agar plates to allow for further growth and analysis. For bacterial strain identification, using MS-MALDI-TOF, each organism, regardless of its morphotype, was identified using this method. A single colony from each sample was collected using a toothpick and placed onto a reusable, barcoded, polished steel MALDI target plate. The plate contained 48 spots filled with a matrix solution, which included acetonitrile, α-cyano-4-hydroxycinnamic acid, and trifluoroacetic acid. Once the samples were air-dried, the target plate was loaded into the MS-MALDI-TOF machine for analysis ( Figure 3).
Additionally, plaque samples were also subjected to PCR (Polymerase Chain Reaction) assay. In this process, the plaque samples were placed in Eppendorf tubes containing 500 𝜇l of sterile phosphate buffer saline (PBS) to preserve the bacterial DNA. These samples were then sent to the microbiological laboratory for assessment. To visualize the PCR products, agarose gel electrophoresis was conducted. The amplified DNA fragments were separated based on size through an agarose gel matrix, and ethidium bromide staining was used to visualize the DNA bands under UV light. Finally, the PCR results were compared to standard molecular markers to verify specific bacterial genes.
After a 3-month follow-up period, plaque samples from the subgingival areas were collected again from the sites previously assessed during the initial baseline examination in both the test as well as control groups. These samples underwent the same microbiological analysis process to assess any changes in the bacterial composition over time.
A total of 34 patients were screened for eligibility, of which 8 were excluded (due to not meeting inclusion criteria, declining to participate, or other reasons). Twenty-six patients were randomized, with 13 allocated to the Chitosan membrane group and 13 to the Tetracycline fiber group. All participants received the allocated intervention, completed follow-up, and were included in the final analysis. The CONSORT flow diagram is presented in Figure 4. Following three months of oral hygiene initiation, patients demonstrated a noteworthy reduction in plaque index (PI). In test group, the mean PI score reduced from 1.58 ± 0.34 at baseline to 1.2 ± 0.17 at three months (p = 0.005), while in the control group, it decreased from 1.71 ± 0.32 to 1.14 ± 0.18 (p < 0.001). A similar trend was observed for the modified sulcus bleeding index (SBI), with the mean SBI score dropping from 1.9 ± 0.2 to 0.97 ± 0.1 in the test group (p < 0.001) and from 1.51 ± 0.49 to 1.06 ± 0.19 in the control group (p = 0.008).
In the test group, the mean PPD decreased from 7 ± 0.82 mm at baseline to 3.15 ± 0.69 mm at three months (p < 0.001), while in the control group, it decreased from 6.92 ± 0.86 mm to 3.15 ± 0.9 mm (p < 0.001). Similarly, the mean CAL in the test group decreased from 6.85 ± 0.8 mm at baseline to 3 ± 0.91 mm at three months (p < 0.001), and in the control group, it decreased from 6.69 ± 0.95 mm to 2.92±0.86 mm (p < 0.001) ( Table 1).
Microbiological analysis revealed several predominant species, including Streptococcus mitis/oralis, Actinomyces israelli, and Fusobacterium nucleatum. While no significant differences were found in the presence of most bacteria between groups, a notable decrease was observed in Aggregatibacter actinomycetemcomitans and Porphyromonas gingivalis in test group after three months on comparison to control group. Specifically, in the test group, the initial detection frequency of A. actinomycetemcomitans decreased from 75% to 25%, and that of P. gingivalis decreased from 50% to 25%. In contrast, the control group maintained a constant detection frequency of A. actinomycetemcomitans at 75%, with P. gingivalis remaining undetected throughout the study period ( Table 2).
The present study aimed to compare the clinical outcomes and antimicrobial effects of 2 mg resorbable chitosan membrane and resorbable tetracycline fibers as adjuncts to SRP in type-2 diabetes mellitus (DM) patients enrolled for periodontal maintenance. The primary objective was to evaluate changes in probing depth (PPD) and clinical attachment level (CAL) with the use of these adjuncts. The secondary objective was to assess their microbiological effects.
All 26 participants completed the study, ensuring complete adherence. A parallel-arm study design was chosen to avoid potential biases from a split-mouth design. Participants were randomly assigned to receive either tetracycline fibers (control arm) or chitosan membrane (test arm) and remained in their assigned treatment arm throughout the study.
The study focused on patients enrolled in a maintenance program as residual pockets, especially those >5 mm in depth, pose a challenge in managing periodontitis.
Diabetes significantly influences periodontitis, increasing its frequency and severity. Local drug delivery (LDD) systems offer advantages over systemic administration, particularly in diabetic patients who may have multiple medications and comorbidities, reducing the risk of drug interactions. Thus, the study targeted type 2 DM patients to leverage the benefits of LDD in managing periodontal diseases in this population.
The present study demonstrated statistically significant improvements in both the test and control groups across the investigated parameters. There was a notable decrease in the full mouth plaque index at the 3-month mark in both groups, with baseline mean plaque indices of 1.58 ± 0.34 and 1.71 ± 0.32 for test and control groups, respectively, decreasing to 1.2 ± 0.17 and 1.14 ± 0.18 at the 3-month follow-up (P = 0.005 and P < 0.001, respectively). Comparing these findings with prior research, Mahmoud et al. (2019)15 observed a highly significant difference in plaque index between baseline and 3 months in their study, which investigated scaling and root planing (SRP) with 1% chitosan gel versus SRP alone. The observed improvements may be attributed to patient motivation, cooperation throughout the study, and the anti-inflammatory effects of chitosan.
The Modified Sulcus Bleeding Index (SBI) exhibited statistical significance in both the test and control groups, with mean SBI values at baseline of 1.9 ± 0.2 and 1.51 ± 0.49, respectively. By the 3-month mark, these values decreased to 0.97 ± 0.1 and 1.06 ± 0.19 for the test and control groups, respectively (P < 0.001 and P = 0.008, respectively), indicating consistent oral hygiene maintenance throughout the study period. In a study by Akincibay et al.,16 where gingival bleeding time index (GBTI) was utilized to assess bleeding, similar results were observed. Their study compared SRP alone to treatment with chitosan gel combined with 15% metronidazole. After 24 weeks, GBTI scores were superior in the chitosan + metronidazole group compared to control, suggesting that the antimicrobial as well as anti-inflammatory properties of chitosan may contribute to reduced gingival bleeding, a common symptom of gingival inflammation.
In the present study, both the test and control groups showed a statistically significant reduction in mean values of probing pocket depth (PPD) and clinical attachment level (CAL) from baseline to 3 months’ follow-up. However, there was no statistical significance in PPD and CAL between the test group (chitosan membrane) and control group (tetracycline fibers), indicating similar effectiveness in improving clinical parameters. Similar observations were noted in a study by Kafle et al. (2019),17 where both SRP alone and SRP with tetracycline fibers showed a substantial decrease in pocket depth between baseline and three months. Studies by Vandekerckhove et al. (1997),18 Kinane et al. (1999),19 and Gonçalves et al. (2004)20 also demonstrated significant decrease in probing pocket depth with the application of tetracycline fibers as an adjunct to SRP. Additionally, a significant increase in clinical attachment level was observed from baseline to the third month of treatment, consistent with findings reported by Newman et al. (1994),21 and Radvar et al. (1996),22 suggesting the potential of tetracycline fibers to enhance clinical parameters. The observed clinical improvements may be attributed to the antimicrobial and anti-inflammatory properties of chitosan, as well as its bioadhesive nature, which supports gingival histological architecture. Tetracycline fibers, through their anti-collagenolytic characteristic and ability to augment collagen production, may contribute to increased clinical attachment level. These findings highlight the efficacy of both chitosan membrane and tetracycline fibers as adjuncts to SRP in improving periodontal parameters in type-2 diabetes mellitus patients.
The present study focused on a special population of type-2 diabetic patients, recognizing the close relationship between diabetes mellitus and periodontal diseases. Diabetes and periodontitis share numerous pathobiological similarities, with diabetes increasing the incidence of periodontitis through physiologically conceivable pathways. Conversely, periodontal diseases may exacerbate insulin resistance, worsening glycemic control. Dodwad et al. (2012)23 evaluated clinical parameters in individuals with type 2 diabetes mellitus, finding that sustained-release resorbable tetracycline fibers led to significantly decreased probing depth compared to SRP alone. While SRP alone is efficient in lowering clinical indices in diabetic individuals, its effectiveness diminishes with pocket depths ≥5 mm. Local administration of tetracycline fibers is preferred over systemic drug administration due to drawbacks like toxicity along with low concentrations in gingival crevicular fluid, as suggested by Kardesler et al. (2010).24 Bolshakov et al. (2021)25 highlighted the role of modified chitosan in bone engineering in diabetes mellitus, emphasizing its ability to control osteoblastogenesis, angiogenesis, and osteoclastic response, thereby promoting the development of new, well-vascularized bone. In another review by Fianza et al. (2020),26 the potential of chitosan nanoparticles coated with curcumin for post-extraction wound healing in type II diabetes patients was discussed. Given the high generation of reactive oxygen species in type II diabetes, chitosan, known for accelerating wound healing, is enhanced in combination with curcumin, offering promising therapeutic benefits.
The study investigated changes in subgingival bacterial load and microbiota composition in periodontitis patients, particularly focusing on Fusobacterium nucleatum. It observed a decrease in bacterial load and qualitative changes consistent with cause-related treatment.27 Despite modest detection rates of F. nucleatum in deep pockets, its association with severe periodontal disease and inflammation was noted.28 MALDI-TOF MS was recommended for accurate microbial identification, revealing heightened prevalence of certain organisms associated with periodontal pathogenesis and type 2 diabetes.29 Demographic profiles, especially glycemic control in type 2 diabetes patients, influenced microbial composition changes, evidenced by increased prevalence of specific organisms over three months.30 Gram staining revealed Gram-negative organisms, undetectable in culture due to growth requirements, validated by PCR analysis confirming the presence of A. actinomycetemcomitans and P. gingivalis.30 PCR assays showed reduction in A. actinomycetemcomitans and P. gingivalis presence post-treatment, contrasting control group findings, aligning with previous studies.31,32 The control group results differed from Kataria et al. (2018), suggesting variations in treatment efficacy.32
The study limitations include the need for a larger sample size to confirm the efficacy of chitosan in maintaining periodontal health in patients with diabetes mellitus. The study’s three-month duration provides only a brief overview of treatment effects; future research might benefit from longer study periods. The use of a single local drug administration session may have contributed to less than optimal results, and the variability in treatment outcomes could be attributed to the potential translocation of periodontal pathogens during the healing period. Additionally, the study did not assess HbA1c levels at baseline and 3 months, which could have provided valuable insight into the correlation between glycemic control and microbiological outcomes. Therefore, future research should consider incorporating these parameters for a more comprehensive understanding of periodontal treatment outcomes in diabetic patients.
Till date, chitosan as local drug delivery agent is not utilized enough in routine dental practice. This is a result of the treatment parameters being poorly specified and the absence of a conventional methodology involving dosimetry or suitable formulations. Therefore, the goal of future research should be to standardise chitosan therapy techniques for treating residual pockets across a broader population.
Ethical approval was obtained from the Institutional Ethics Committee of Manipal College of Dental Sciences Mangalore, Manipal Academy of Higher Education, Manipal (Protocol reference number: 22038). The trial was registered prospectively with the Clinical Trials Registry – India (Trial REF/2022/04/053476; Registration number: CTRI/2023/10/058766). Participants were enrolled after providing written informed consent and receiving a comprehensive explanation of the procedures, benefits, and potential risks.
Figshare. Underlying data for “Targeted Therapy with Chitosan vs. Tetracycline: Exploring New Frontiers in Periodontal Care for Diabetic Patients Undergoing Maintenance Therapy”. https://doi.org/10.6084/m9.figshare.30120472.v233
This project contains the following underlying data:
• CONSORT_Checklist_Chitosan_vs_Tetracycline.pdf (Completed CONSORT 2025 checklist for the study)
• CONSORT_Flowchart_Chitosan_vs_Tetracycline.pdf (Flow diagram of participant enrollment, randomization, allocation, follow-up, and analysis)
• Table 1_ClinicalParameters.xlsx (Raw clinical parameter data: PI, SBI, PPD, CAL)
• Table 2_MicrobiologicalParameters.xlsx (Raw microbiological culture and PCR data)
Data are available under the terms of the Creative Commons Attribution 4.0 International License (CC BY 4.0).
Figshare. Underlying data for “Targeted Therapy with Chitosan vs. Tetracycline: Exploring New Frontiers in Periodontal Care for Diabetic Patients Undergoing Maintenance Therapy”. https://doi.org/10.6084/m9.figshare.30120472.v233
This project contains the following underlying data:
• CONSORT_Checklist_Chitosan_vs_Tetracycline.pdf (Completed CONSORT 2025 checklist for the study)
• CONSORT_Flowchart_Chitosan_vs_Tetracycline.pdf (Flow diagram of participant enrollment, randomization, allocation, follow-up, and analysis)
• Table 1_ClinicalParameters.xlsx (Raw clinical parameter data: PI, SBI, PPD, CAL)
• Table 2_MicrobiologicalParameters.xlsx (Raw microbiological culture and PCR data)
Data are available under the terms of the Creative Commons Attribution 4.0 International License (CC BY 4.0).
Trial registration: Clinical Trials Registry – India (CTRI), REF/2022/04/053476; CTRI/2023/10/058766.
| Views | Downloads | |
|---|---|---|
| F1000Research | - | - |
|
PubMed Central
Data from PMC are received and updated monthly.
|
- | - |
Is the work clearly and accurately presented and does it cite the current literature?
Partly
Is the study design appropriate and is the work technically sound?
Yes
Are sufficient details of methods and analysis provided to allow replication by others?
Yes
If applicable, is the statistical analysis and its interpretation appropriate?
Partly
Are all the source data underlying the results available to ensure full reproducibility?
Yes
Are the conclusions drawn adequately supported by the results?
Partly
Competing Interests: No competing interests were disclosed.
Reviewer Expertise: Biomedical, Oral Biology, Public Health, Implantology, Gerodontology, Stomatology
Is the work clearly and accurately presented and does it cite the current literature?
Partly
Is the study design appropriate and is the work technically sound?
Partly
Are sufficient details of methods and analysis provided to allow replication by others?
Partly
If applicable, is the statistical analysis and its interpretation appropriate?
Partly
Are all the source data underlying the results available to ensure full reproducibility?
Yes
Are the conclusions drawn adequately supported by the results?
Partly
Competing Interests: No competing interests were disclosed.
Reviewer Expertise: Periodontics, Microbiology of periodontal disease, host modulations, periodontal disease and systemic health, natural bioactive compounds in the periodontal therapy
Alongside their report, reviewers assign a status to the article:
| Invited Reviewers | ||
|---|---|---|
| 1 | 2 | |
|
Version 1 24 Nov 25 |
read | read |
Provide sufficient details of any financial or non-financial competing interests to enable users to assess whether your comments might lead a reasonable person to question your impartiality. Consider the following examples, but note that this is not an exhaustive list:
Sign up for content alerts and receive a weekly or monthly email with all newly published articles
Already registered? Sign in
The email address should be the one you originally registered with F1000.
You registered with F1000 via Google, so we cannot reset your password.
To sign in, please click here.
If you still need help with your Google account password, please click here.
You registered with F1000 via Facebook, so we cannot reset your password.
To sign in, please click here.
If you still need help with your Facebook account password, please click here.
If your email address is registered with us, we will email you instructions to reset your password.
If you think you should have received this email but it has not arrived, please check your spam filters and/or contact for further assistance.
Comments on this article Comments (0)